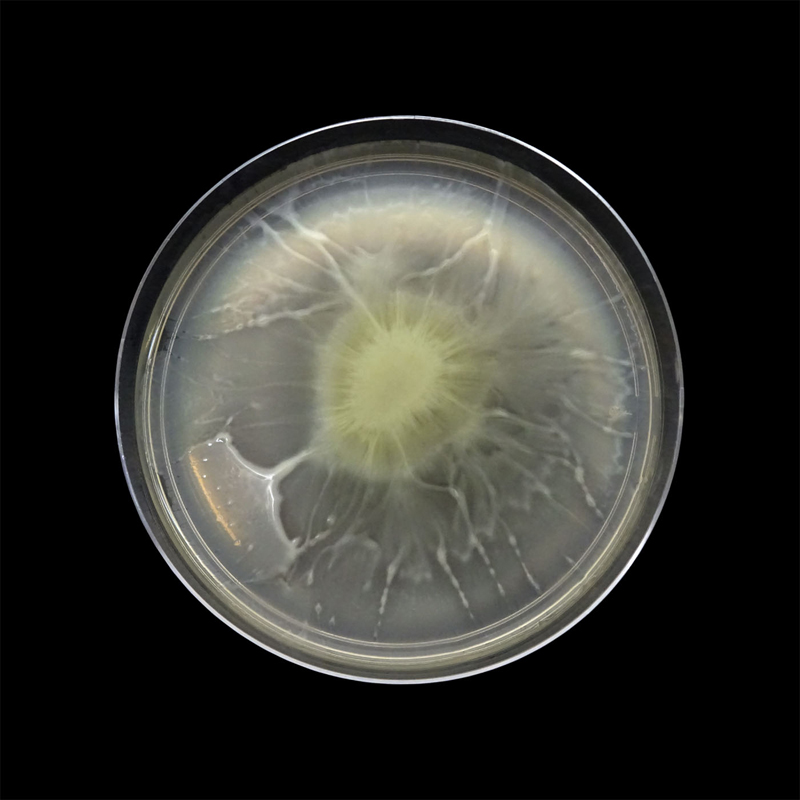

|
THE UNIVERSE IN DETAILS FROM THE CRITICAL MEMBRANE SERIES ARCHIVAL PRINTS ON HAHNEMUHLE MUSEUM ETCHING 2016 |
|
 | |
|
'Critical Membrane' marks the current phase of Sonia Mehra Chawla's ongoing project, 'Scapelands', and her close engagement with the present and future of India's endangered mangrove systems. Spanning prints, photographs, video works and installations, this body of work addresses itself to the mangrove ecologies of India's Coromandel and Malabar coasts, located respectively in the states of Tamil Nadu and Kerala. The artist's exploration of these regions has been inspired by an awareness of impending ecological catastrophe. The mangroves, an osmotic border between land and sea, are under grave threat from direct human interference as well as the cataclysmic shifts in a natural world disordered by the long-term effects of technological activity. In Mehra Chawla's elegiac images of dying mangroves and shrinking wetlands, we find the chronicle of many deaths foretold. 'Critical Membrane' reminds us of the epochal costs that humankind must pay for its economic expansionism, a logic set in motion during the industrial revolution and supported by the contractarian ideology and extractive practices of global capital. As the philosopher Akeel Bilgrami has memorably phrased it, this paradigm has replaced nature with natural resources, communities with populations, and the knowledge to live by with an expertise to rule by. This instrumentalisation of our lifeworld follows from the industrialisation-era model of pitching humankind against nature. By contrast, research across a range of disciplines has encouraged us, with increasing urgency in recent decades, to embrace the understanding that we inhabit complex webs of stimulus and response, intervention and repercussion. We are bound together by interrelationships that require sensitive calibration but are treated, all too often, with shockingly callous and ultimately self-destructive disregard. Suggestive of the fluid boundary between self and other, species and habitat, the title of Mehra Chawla's exhibition alerts us to the need to subject our visions of anthropocentric, nature-depletive development,to critique. The artist's practice combines a commitment to the processes of research and activism with a fidelity to the poetics of the artwork. In bearing witness to an unprecedented moment in the history of the planet, she brings together a variety of impulses, ranging from microscopic details of bacterial and microbial cultures to documentary cinematic studies of marginalised groups whose eco-sensitive occupations have suffered as a result of the decline in their environment. While I have argued, previously, that there is a strongly solitary, expeditionary quality to Sonia Mehra Chawla's projects, I would also draw attention to the equally vital collaborative and empathetic aspects of her work. Her thread through the labyrinth is woven together with the threads of other questors, other survivors, other celebrants of resistance. - Ranjit Hoskote http://www.aestheticamagazine.com/yinchuan-biennale-2016/ | |
|
Exploring the culturable microbial diversity of this less explored ecosystem. (Several strains of bacteria were especially cultured by scientists in the MSSRF laboratories for 'Critical Membrane' and were all documented by the artist in the laboratory's UV laminar flow cabinets to prevent contamination of experiment. A few bacterial samples were collected from the PHD students at MSSRF. A few contaminated bacteria samples were also documented for the project.) The mangrove ecosystem is one of the most productive ecosystems and is the habitat for a large number of organisms. The microbial community of this ecosystem contributes to the bio-geochemical cycle and nutrient transformation by various mechanisms like degradation of complex molecules, ammonification, nitrification, dentritification as well as to carbon flux and methane utilization. Unveiling the diversity and structure of microbial communities in mangrove environments is the first step in understanding their role in the functioning of this ecosystem. The rhizosphere microorganisms contribute to the productivity of the mangroves; and also maintain plant heath and overall ecosystem resilience. | |
 |
 |
 |
||
 |
 |
 |
||
 |
 |
 |
||
 |
 |
 |
||
 |
 |
 |
||
 |
 |
 |
||
|
 |
|||